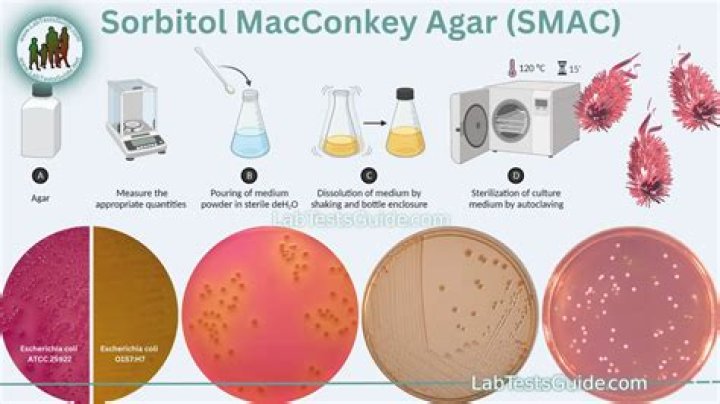

What is a McConkey turn?
For Rahlves, the move is now as ingrained into racing as it is freeskiing, where it's known as the slarve, or the “McConkey turn.” The difference he...
Knowledge Base
Latest insights and tutorials from the Clarity News Hub team.
How can I stop vomiting immediately?
What can be done to control or relieve nausea and vomiting?Drink clear or ice-cold drinks.Eat light, bland foods (such as saltine crackers or plain bread...
Read More →Who invented lawn tennis?
Who invented the game of tennis? The inventor of modern tennis has been disputed, but the officially recognized centennial of the game in 1973 commemorat...
Read More →Who breaks Haradhanu?
Thanks. The breaking of "Haradhanu" by Ramji wasn't done intentionally. The condition laid down by king Janak is that who-ever lifts and strings the...
Read More →What is a 28 handicap in golf?
A Generic Handicap The more general way to find a not-so-reliable handicap is by simply counting the number of strokes you are over par on a course. If y...
Read More →How many sit-ups a day does it take to get a six pack?
According to Livestrong, combining three sets of sit-ups with 25 to 50 repetitions each is how to build and sculpt your abs. Better still, you only need ...
Read More →How much time will a standard documentary take?
In a nutshell, it typically takes 2-3 months or more to make a documentary. This time is in three phases: Pre-production, Production, and Post-production...
Read More →How high can a caracal leap?
A Caracal's Incredible Vertical Launch Caracals are adapted to catch birds in flight and capable of leaping up to 3m high. Which jumps higher serval...
Read More →Do Nascars use regular gas?
NASCAR engines burn 110-octane leaded gasoline. Indy cars burn pure methanol (a.k.a. wood alcohol, CH3OH). Top Fuel dragsters and funny cars burn nitrome...
Read More →Is it a stolen base if there is no throw?
If no throw is made it may be scored as a stolen base, or as defensive indifference (DI). Is it a stolen base if no throw? A stolen base doesn't nee...
Read More →